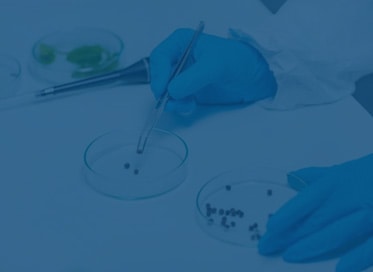
Genetic Risk Evaluation & Testing Program in El Paso, Texas

Q Med Laboratory, LLC

Q Med Laboratory's Genetic Testing Texas Risk Evaluation and Testing Program in El Paso, Texas, & surrounding areas can assist you to identify if any increased risk for cancer
Q Med Laboratory, LLC
From the Author
Related Articles
Westside Dentistry Stephen J. Kimball, D.M.D. 2023-09-26

Importance of Choosing the Right Dentist in El PasoWhen it comes to your dental health, choosing the right dentist is of utmost importance. Whether you are new to El Paso or have lived here your entire life, finding a reliable dentist who meets your specific dental needs is crucial. Understanding Your Dental NeedsBefore starting your search for a dentist in El Paso, it is essential to understand your specific dental needs. Being aware of your dental needs is the first step toward finding the right dentist in El Paso. The Importance of Regular Dental Check-UpsOnce you have chosen the right dentist in El Paso, make sure to schedule regular dental check-ups as recommended by your dentist.

0

0
digitalmarketingservicesfirm 2022-04-23

Best Largest El Paso Seo Agency1. What is the one watchword express you'd like the page to appear for when somebody does an inquiry? The title Meta-tag is ostensibly one of the main "value for your money" El Paso Seo Agency advancements you have some control over. The free web page checkers will give a rundown of conceivable code messes up that should be fixed. At a Search Engine Strategies meeting in San Jose, CA; search marketing experts discussed and talked about if figuring out search calculations was the appropriate technique for SEO or whether website watchers were the main part of a El Paso Seo Company crusade.

0

0
Repair Printer 2023-11-21

Experts will help you not only for small printer machine issues but also provide extensive help for driver update, errors , printer not working, printer printing black and white or whatever issue in El Paso. No need to go anywhere, let's find Printer technicians El Paso near by location. It's very easy to search to find Printer technician El Paso near me. Quick inspection and solutions within 2 hours. Connect with certified printer technicians at the El Paso location over the phone. Experts will help you not only for small printer machine issues but also provide extensive help for driver update, errors , printer not working, printer printing black and white or whatever issue in El Paso. No need to go anywhere, let's find Printer technicians El Paso near by location. It's very easy to search to find Printer technician El Paso near me. Quick inspection and solutions within 2 hours.

0

0
You might like